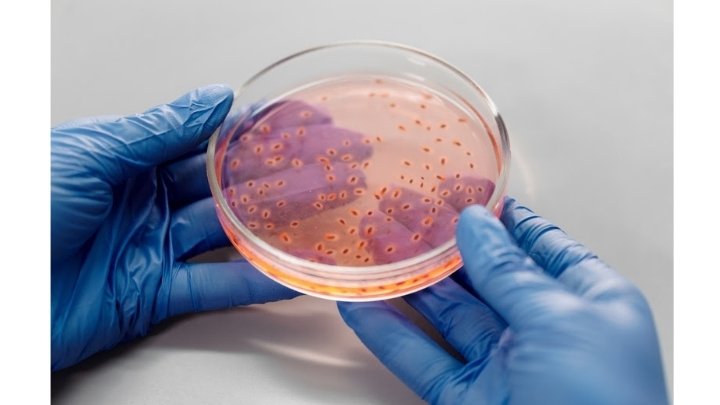

Semana Mundial de Conscientização sobre Antimicrobianos
Instituições referências em saúde se unem para combater superbactérias
Número de bactérias resistentes triplicou durante a pandemia e projeto inédito auxilia hospitais a reduzirem infecções
Os casos registrados de bactérias resistentes a antibióticos saltaram de um pouco mais de mil para 3,7 mil entre 2019 e 2021. Para ajudar a reverter este cenário, o Hospital Angelina Caron, referência em atendimentos de alta complexidade no país, e a BD uma das maiores empresas de tecnologia médica do mundo, se uniram numa iniciativa para promover o uso racional de antibióticos e reduzir infecções no ambiente hospitalar — que inclusive podem levar a óbito.
O Programa de Antimicrobial Stewardship, que visa promover o uso racional de antibióticos, começa a apontar os primeiros resultados positivos, ainda que preliminares. “Em menos de duas semanas após a implementação, já realizamos 50 intervenções em prescrições de antibióticos na UTI, ou seja, 50 pacientes tiveram o uso de medicamentos otimizado, nas dosagens e durações”, explica o médico infectologista Ricardo Kosop, coordenador do projeto no HAC.
A implantação completa do programa dura em torno de 12 meses e conta com apoio da BD, que possui tecnologia de ponta para identificação de bactérias dentro de instituições de saúde.
“Por meio desse programa inédito, queremos ajudar as instituições a identificarem e traçarem um perfil das bactérias presentes em cada hospital. A partir daí, é possível oferecer tratamento personalizado para cada pacientes, evitando que doses desnecessárias de medicamentos sejam utilizadas”, diz Luis Fernando, diretor de Negócios IDS, da BD.
Sobre a BD
A BD é uma das maiores empresas de tecnologia médica do mundo que está impulsionando o mundo da saúde ao investir na descoberta médica, no diagnóstico e na prestação de cuidados com a saúde humana e animal. A empresa apoia os profissionais que estão na linha de frente dos cuidados da saúde por meio do desenvolvimento de tecnologia, serviços e soluções inovadoras que ajudam a avançar na terapia clínica para pacientes e no processo clínico para os prestadores de cuidados de saúde. Para mais informações, acesse o site
Sobre o Hospital Angelina Caron
O Hospital Angelina Caron tem como missão atender plenamente os seus mais diversos públicos, de forma igualitária, humanizada e integral. Localizada ao lado de Curitiba, em Campina Grande do Sul, a instituição é um centro médico-hospitalar de referência no Sul do Brasil. Tem como pilares os mais rigorosos princípios éticos e o compromisso social, além de 39 anos de tradição para oferecer a melhor promoção em saúde e possibilitar a retomada da qualidade de vida. O HAC realiza mais de 400 mil atendimentos por ano em pacientes de todo o país, incluindo particulares e por convênios, sendo um dos maiores parceiros do SUS no Estado. Com investimentos frequentes em tecnologia e equipamentos de última geração, o hospital atua em todas as vertentes da medicina, conta com Serviço de Transplantes de Órgãos reconhecido internacionalmente e é um centro tradicional de fomento ao ensino e à pesquisa.

